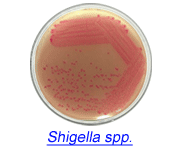
shigella.gif
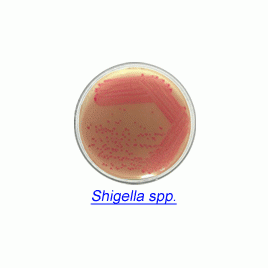

Product
제품
소개
Rainbow® Agar Shigella/Aeromonas (Dehydrated Media)
Chromogenic Media for Microbial Detection Less than 24 Hours
Rainbow Agar Shigella/Aeromonas was developed to provide laboratories with a better culture medium for directly isolating pathogenic strains of Shigella and Aeromonas.
The medium is inhibitory to gram-positive bacteria and most non-enteric gram-negative bacteria, but is not toxic to the target species. Escherichia coli is significantly inhibited, and colonies that grow are blue.

주문정보
80302 Rainbow® Agar Shigella/Aeromonas 71.5 g packet (approx. 50 plates)
관련자료